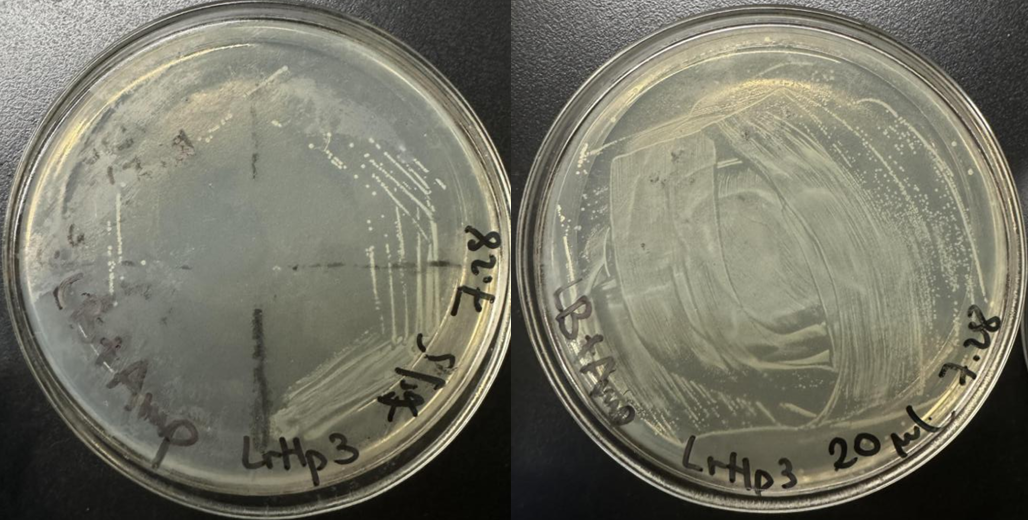
图片

1. Introduction
1.1. Current previous wastewater treatment method
Water is one of the most important resources that people use in everyday life. Wastewater treatment plays an important role in supporting urban life. Current technologies are sufficient to provide fundamental functions, but they often contain drawbacks that need other solutions. One of the crucial processes in wastewater treatment is the uptake of nitrogen and phosphorus. Current wastewater treatment often uses bacteria as a tool to dissolve excessive nitrogen and phosphorus in the municipal wastewater, preventing eutrophication after it is released as effluents [1]. However, the current process emits large amounts of carbon dioxide and consumes large amounts of oxygen as bacteria process through cellular respiration. Bacteria also create lots of sludge after treatment. The sludge often gets buried or burned, but it all creates secondary pollution to the air and land [2].
1.2. Current algae treatment technology
As sustainable development has become a goal to reach over the past years, many companies have started to explore the wastewater treatment function of many other organisms, including algae, which are known to have ecosystem services of water treatment in the wetland ecosystem. Through years of research, people have discovered algae’s potential in wastewater treatment, such as Chlorella Vulgaris, which could remove more than eighty percent of total nitrogen and one hundred percent of total phosphorus within thirteen days [3,4]. These algae work well in the laboratory, but they face many application problems, such as harvesting issues where algae clusters are too small to condense, and algae are also growing too slowly, which would not reach real-world application levels. People have found solutions for the harvesting problem, in which we cultivate species of Chlamydopodium sp. and Leptolyngbya_PCC-6306 [5]. Two species bind together to form a bigger cluster named photogranules that can be easily condensed and harvested in a short time. Leptolyngbya_PCC-6306 is a linear-shaped cyanobacterium that is mainly used to support the large cluster structure, and Chlamydopodium sp. is a spherical green algae that is responsible for nitrogen and phosphorus uptake. However, this structure is not stable as it only remains when the Chlamydopodium sp. to Leptolyngbya_PCC-6306 ratio is 30 to 1. Leptolyngbya_PCC-6306 grows at a much faster rate than cyanobacteria, which makes the cluster shape unstable.
1.3. Current problem
The current problem for algae wastewater treatment is that the natural growth rate of green algae cannot be accommodated by the current wastewater treatment process. The current wastewater treatment process sets six to eight hours of treatment time in the biological treatment section, where bacteria are used [6,7]. However, algae need more than three days to treat the water to a releasable standard, which is much more than the time needed before. Also, the low growth rate of green algae poses a challenge to the previous study to maintain the 30:1 ratio between green algae and cyanobacteria [5].
1.4. Research aim
Nitrogen systems were believed to be the most crucial nutrient for algae growth [8]. This research aims to increase Chlamydomonas reinhardtii (C. reinhardtii)’s growth rate by overexpressing genes of NRT1, NR, and NiR, which stimulate nitrogen consumption in algae and increase their transformation from NO3 to a usable nitrogen source [9]. With abundant nitrogen sources in the wastewater body, overexpressing Nitrogen Reductase allows algae to have more usable nutrients, supporting larger nitrogen requirements as they grow faster. Hypothesizing that the overexpression of NRT1, NR, and NiR can increase the nitrogen uptake rate and the growth rate of algae, plans were made to overexpress these genes by constructing a plasmid as a vector to transform into the organism, and a comparison test is conducted comparing the engineered organism to the wild type to examine this hypothesis. Wild type will be set in the exact condition, with the same temperature, same nutrients, and the same light as the engineered ones, and their growth rate will be calculated based on the daily concentration measured using a spectrophotometer.
2. Material and methods
2.1. Algae strain
In the cyanobacteria and green algae combination, green algae have a lower growth rate, which makes the cluster unstable. Since Chlamydopodium sp. was less utilized in previous research and has limited availability from the market, C. reinhardtii demonstrated in Figure 1, which is a strain highly similar to Chlamydopodium sp. and is largely studied for biofuel production, was used.

2.2. Gene extraction
C. reinhardtii has a cell wall, so grinding inside liquid nitrogen is needed to break the cell wall before extracting the genome using a DNA extraction kit.
The genome for C. reinhardtii has lots of exons and introns, which makes the whole genome long. To ensure the PCR process, cDNA is used as the template for PCR. RNA is extracted from C. reinhardtii, and the concentration is measured using a spectrophotometer to ensure the quality of the RNA. The ratio of A260 to A280 should be around 2.0. RNA is then reverse transcribed to cDNA, where only introns exist.
The genome of C. reinhardtii has a high GC content. So, a 5-minute 62 °C water bath is added after the template and primer are added to the tube. The temperature in reverse transcription is adjusted from a 42 °C water bath for 30 minutes to a 50 °C water bath for 60 minutes.
2.3. Plasmid design
C. reinhardtii normally uses Hsp70 and RbcS2 as a promoter and Zeocin to select. pChlamy/Cre and pPTGE34 was used to construct a plasmid with Hsp70 and Rbc S2 promoter and Zeocin



Figure 4: A design for plasmid based on backbone from pChlamy/Cre, and Zeocin Resistance from pPtGE34

In case of unexpected challenges, there were two designs that were based on pChlamy/Cre and pPtGE34 backbones, respectively. For the first design shown in Figure 4, the origin and Hsp 70 promoter come from the pChlamy backbone, and the range included in this fragment is demonstrated with red marks and blue marks in Figure 2, respectively,. The zeocin resistance gene is from the pPtGE34 plasmid fragment shown in green in Figure 3. The second design is based on the origin provided by the pPtGE34 backbone fragment shown with a red mark in Figure 3, and uses the same Hsp 70 promoter as the first design. The designs are shown in the following figures (Fig.4 & Fig.5)

In Figure 6, the plasmid is designed with NdeI and Spe I restriction enzyme cutting site around the target gene intersection region. In this experimental design, target gene is extracted from the genome using primer with overhang containing restriction enzyme site.
2.4. Primer design
To get fragments as designed, we need to design a primer, and with so many fragments to connect, Gibson assembly will be the best choice for this purpose. So, primers were designed with an overhang that ensures Gibson assembly.
The template used is cDNA, which means it only exists in exons. The primers were designed within 20 base pairs after the start codon, and 20 base pairs before the stop codon.
|
Name |
Sequence (5' to 3') |
Length |
%GC |
Tm |
|
pChlamy-B-f-NRT1 |
CTGCCTGCGCCCTTCAGGTAGCTCTGCAGCGGCCGCCATAT |
41 |
65.8 |
76.9℃ |
|
pChlamy-B-f-NR |
CAAGGACCGCCAGATCCAGTTCTAGCTCTGCAGCGGCCGCCATAT |
45 |
60.0 |
75℃ |
|
pChlamy-B-f-NiR |
GCCACCGCCACCGCCTAACTCTGCAGCGGCCGCCATAT |
38 |
68.4 |
77.3℃ |
|
pChlamy-B-r |
GAAGATCCACTAGTTCTAGAGCGGCGTCGGGAAACCTGTCGTGCC |
45 |
57.8 |
72.7℃ |
|
Zeocin-Promoter-f |
GGCACGACAGGTTTCCCGACGCCGCTCTAGAACTAGTGGATCTTC |
45 |
57.8 |
72.7℃ |
|
Zeocin-Promoter-r |
GCACTGGTCAACTTGGCCATGGGTCCTCGAATCTCCTGCAAATG |
45 |
53.3 |
71.6℃ |
|
Zeocin-f |
CATTTGCAGGAGATTCGAGGTACCCATGGCCAAGTTGACCAGTGC |
45 |
53.3 |
71.6℃ |
|
Zeocin-r |
GAAGATCCACTAGTTCTAGAGCGGCCGCCTCGTATCTTTTAATGATGG |
48 |
47.9 |
68.9℃ |
|
pChlamy-Target-P-f |
CCATCATTAAAAGATACGAGGCGGCCGCTCTAGAACTAGTGGATCTTC |
48 |
47.9 |
68.9℃ |
|
Target-P-r-NRT1 |
CCGTCTCGCCGTCTTGACATGGGTCCTCGAATCTCCTGCAAATG |
45 |
55.6 |
72.1℃ |
|
Target-P-r-NR |
GGCTGCTCGGCAACGGTCATGGGTCCTCGAATCTCCTGCAAATG |
45 |
57.8 |
73.6℃ |
|
Target-P-r-NiR |
AAGCACTGGCGCGACTGCATGGGTCCTCGAATCTCCTGCAAATG |
45 |
55.6 |
73.6℃ |
|
Target-f-NRT1 |
CATTTGCAGGAGATTCGAGGTACCCATGTCAAGACGGCGAGACGG |
45 |
55.6 |
72.1℃ |
|
Target-f-NR |
CATTTGCAGGAGATTCGAGGTACCCATGACCGTTGCCGAGCAGCC |
45 |
57.8 |
73.6℃ |
|
Target-f-NiR |
CATTTGCAGGAGATTCGAGGTACCCATGCAGTCGCGCCAGTGCTT |
45 |
55.6 |
73.6℃ |
|
pChlamy-T-r-NRT |
ATATGGCGGCCGCTGCAGAGCTACCTGAAGGGCGCAGGCAG |
41 |
65.8 |
76.9℃ |
|
pChlamy-T-r-NR |
ATATGGCGGCCGCTGCAGAGCTAGAACTGGATCTGGCGGTCCTTG |
45 |
60.0 |
75℃ |
|
pChlamy-T-r-NiR |
ATATGGCGGCCGCTGCAGAGTTAGGCGGTGGCGGTGGC |
38 |
68.4 |
77.3℃ |
|
pPtGE34-B-f-NRT1 |
CTGCCTGCGCCCTTCAGGTAGCGACTTTGGCTGGGACACTTTCA |
44 |
59.1 |
74.7℃ |
|
pPtGE34-B-f-NR |
CAAGGACCGCCAGATCCAGTTCTAGCGACTTTGGCTGGGACACTTTCA |
48 |
54.2 |
73℃ |
|
pPtGE34-B-f-NiR |
GCCACCGCCACCGCCTAACGACTTTGGCTGGGACACTTTCA |
41 |
61.0 |
74.9℃ |
|
pPtGE34-B-r |
GAAGATCCACTAGTTCTAGAGCGGCGTAACTTACACGCGCCTCGTATCTT |
50 |
50.0 |
71℃ |
|
pPtGE34-T-P-f |
AAGATACGAGGCGCGTGTAAGTTACGCCGCTCTAGAACTAGTGGATCTTC |
50 |
50.0 |
71℃ |
|
pPtGE34-T-r-NRT1 |
TGAAAGTGTCCCAGCCAAAGTCGCTACCTGAAGGGCGCAGGCAG |
44 |
59.1 |
74.7℃ |
|
pPtGE34-T-r-NR |
TGAAAGTGTCCCAGCCAAAGTCGCTAGAACTGGATCTGGCGGTCCTTG |
48 |
54.2 |
73℃ |
|
pPtGE34-T-r-NiR |
TGAAAGTGTCCCAGCCAAAGTCGTTAGGCGGTGGCGGTGGC |
41 |
61.0 |
74.9℃ |
In Table 1, the report has shown a high GC content and high annealing temperature for the primers. High annealing temperature can make gene targeting hard, especially when some of it is higher than the extension temperature in phase three of PCR, which is 72 degrees Celsius. To ensure accurate gene targeting from the C. reinhardtii genome, two alternative plans were designed. Alternative plan one is to have the higher quality primers in Table 2 that is further from the start codon to get the target gene roughly. Then, use the previous set of primers with overhang to enable Gibson assembly to connect the fragments. Alternative plan two is using plasmid three, which previously had restriction enzymes Nde I and Spe I cutting sites around the target gene intersection area. Table 3 shows the new primers designed with Nde I and Spe I cutting sites.
|
Name |
Sequence (5' to 3') |
Length |
%GC |
Tm |
|
NRT1-f-1 |
CAAGAATGTCAAGACGGCGAG |
21 |
52.4 |
56.5℃ |
|
NRT1-r-1 |
GCTGCCGCCTCTTGCTTCCTC |
21 |
66.7 |
63℃ |
|
NRT1-f-2 |
AGAATGTCAAGACGGCGAGACG |
22 |
54.5 |
59.6℃ |
|
NRT1-r-2 |
CTGCCGCCTCTTGCTTCC |
18 |
66.7 |
58.5℃ |
|
NR-f |
CCAGTATGACCGTTGCCG |
18 |
61.1 |
55.6℃ |
|
NR-r |
CTGTGCCAGCCCTTATCC |
18 |
61.1 |
54.8℃ |
|
NiR-f |
AAATAACCCGAGGCTTGTG |
19 |
47.4 |
52.7℃ |
|
NiR-r |
TCGCTCCAAACACCAACG |
18 |
55.6 |
55.7℃ |
|
Name |
Sequence(5’ to 3’) |
Length |
%GC |
Tm |
|
NRT1-f-res |
CATATGTCAAGACGGCGAGACGG |
23 |
56.5 |
60.1℃ |
|
NRT1-r-res |
ACTAGTCTGCCGCCTCTTGCTTCCTC |
26 |
57.7 |
64.1℃ |
|
NiR-f-res |
CATATGCAGTCGCGCCAGTGCTT |
23 |
56.5 |
62.8℃ |
|
NiR-r-res |
ACTAGTTCGCTCCAAACACCAA CGCT |
26 |
50.0 |
63℃ |
|
NR-f-res |
CATATGACCGTTGCCGAGCAGCC |
23 |
60.9 |
62.9℃ |
|
NiR-r-res |
ACTAGTCTGTGCCAGCCCTTATCCGG |
26 |
57.7 |
63.7℃ |
2.5. Link method
Gibson assembly is used in the first two plasmid constructions. The first two plasmid designs with pxy/Cre and pPtGE34 as backbones involved the synthesis of many fragments, which made the common application of restriction enzymes challenging due to a design challenge that required checking if the enzyme uses only one targeted site. The short binding site of the restriction enzyme can make it unspecific, which increases the chance of a binding error. Gibson assembly is used in the design of the first two plasmids, since Gibson assembly ensures a binding of more than 20 base pairs between the overhangs of primers.
A restriction enzyme is used in the third plasmid construction. The plasmid backbone of pDb124-HpERF3 already involves Zeocin resistance and promoter for C. reinhardtii. There are existing Nde I and Spe I restriction enzyme cutting sites around the target gene intersection area. Restriction enzyme is applied in this case as it does not require as long an overhang as Gibson assembly did, ensuring primer quality.
2.6. Transformation
Electroporation is one of the most common transformation methods, which only requires common lab equipment. It is suitable for C. reinhardtii due to its ability to break through the thick cell wall.
2.7. Result testing
C. reinhardtii can survive in ampicillin even when the plasmid we designed does not exist in the cell. Zeocin was used to select cells with a plasmid. C. reinhardtii will be cultivated on a petri dish with SE as a nutrient and Zeocin as an antibiotic. Cells that have a plasmid inside will be able to survive on the plate. A single colony from the plate was picked and cultivated for expansion.
A comparison test is then set to test if overexpressing the gene will work. We cultivated the transformed C. reinhardtii with the natural one and in the same absolute environment, and recorded their OD680 to test their concentration change.
3. Data and analysis
3.1. Gene extraction
|
A260 |
A280 |
A260/A280 |
Dilution Factor |
Concentration (ng/μL) |
|
|
RNA |
0.703 |
0.383 |
1.857 |
15x |
421.8 |
The RNA sample demonstrated in Table 4 is extracted without using liquid nitrogen, using only the RNA extraction kit. The absorption under wavelengths of 260nm and 280nm is measured using a spectrophotometer, and the concentration is calculated using the A260 value multiplied by 40, and multiplied by diluted times.
The cell wall of C. reinhardtii might decrease the efficiency of the RNA extraction, so this experiment was performed again with pre-treatment of grinding using mortar in liquid nitrogen, and the result is shown in Table 5. Comparing results shown in Table 4 and Table 5, the concentration of RNA, the concentration of sample extracted with pre-treatment appear to be higher.
|
A260 |
A280 |
A260/A280 |
Dilution Factor |
Concentration (ng/μL) |
|
|
RNA |
0.795 |
0.428 |
1.857 |
15x |
477 |
3.2. Plasmid extraction and cultivation
In Figure 7, the cultivation on the petri dish showed that to get a clear single colony, this plasmid stored in glycerol stock is best cultivated using streak plating. The results of plasmid extraction are shown in Table 6.
|
A260 |
A280 |
A260/A280 |
Dilution Factor |
Concentration (ng/μL) |
|
|
pDb124-HpERF3 (Single) |
0.127 |
0.083 |
1.53 |
30x |
190.5 |
|
pDb124-HpERF3 (5) |
0.126 |
0.082 |
1.537 |
30x |
189 |
3.3. PCR

The variable that changed among the samples used in Figure 8 is the annealing temperature. None of them showed obvious signals, but we can see that the signals for Zeocin are getting better as the temperature decreases. Higher annealing temperature may increase specificity, and lower annealing temperature may increase production. Fig. 8a) and b) show no smear shape, so the annealing temperature is decreased to increase the production of the sample. However, no obvious improvements in DNA band quality was noted.

The variable that changed among the sample used in two gel-electrophoresis shown in Figure 9 is the annealing temperature and the amount of template. The annealing temperature had been increased to the lowest Tm of the primer part without overhang. The temperature was increased to increase specificity. There are obvious signals shown around 1300bp for NRT and NR. The length does not match the target gene length, but this discrepancy may be due to splicing that changes the expressed sequence. This sample was sent to the test sequence, but the result showed no similarity between the tested sample and the target gene.
Previous experiments were run at high annealing temperatures, as the high GC content and the overhang had significantly increased the Tm for primers. New sets of primers were designed with lower annealing temperatures and higher quality.

The variables in this set of experiments include the annealing temperature and the template. The previous experiment with cDNA as a template did not give a correct DNA band. The experiment demonstrated in Fig.10(B) using the genome as a template has eliminated possible flaws in the template since it also did not give the band with the targeted length. The signal of two weak bands is amplified in the experiment demonstrated in Fig.10(C). The two strong bands were extracted and sent to the test sequence, but the result comes back with no similarity to the target gene.

These experiments have shown a strong DNA band with a length close to the target length, but none of them was the target gene after sequence testing. The annealing temperature was kept constant in these three experiments. Experiments shown in Fig.11b and Fig.11c aimed to amplify clear signals. However, the signals for NiR cannot be cleared; it always shows two bands.
The sequencing result shows that the sample is not the target gene, but it is not similar to the previous sequencing result either. Through blasting the primers, many other proteins’ sequences have been found to show similarity, which shows the high similarity between these proteins. This led to the failure to obtain the targeted gene from the cDNA.
4. Future directions
4.1. Reflection
As previously planned, the experiments progressed well, with each small experiment feasible and doable for obtaining the whole genome and cDNA. However, the experiment stopped at a crucial step: obtaining the target gene from the cell body. The reason for not obtaining the target gene from cDNA is that it neglected the actual introns eliminated during the splicing process, where the matching code of the primer might not exist in the cDNA. However, even using the genome as a template, the target gene cannot be found. This is due to the high GC content in this organism, which causes high similarity in gene code for many proteins in this organism. Although the primers were designed to match the target gene’s ends perfectly, the sequencing results indicate that the primers bind to gene sequences that match approximately eighty percent, suggesting the primer is not sufficiently specific to target the gene. The high similarity in the gene sequence made it challenging to obtain from the organism; for the new plans to overcome this problem, artificially synthesizing it should be the best choice. Having long primers to perform Gibson assembly will be problematic, since synthesizing the DNA artificially, using restriction enzyme sites NdeI and Spe I, will be more efficient.
4.2. Gene recombinance
C. reinhardtii is an eukaryotic cell that does not naturally have a plasmid in its cell. They could only temporarily express the gene in the plasmid, and this cannot be inherited. To prolong the ability to consume large amounts of nitrogen and achieve a fast growth rate, the code to overexpress the gene should be added to the genome. Thus, the trait could exist for a long time and be inherited. To achieve this purpose, we need to use the Transposon System, where the added gene is randomly inserted into C. reinhardtii’s genome [12]. This method is better than other commonly seen methods, such as homologous recombination and viral infection. This is because homologous recombination has low efficiency in C. reinhardtii, as it needs to target a specific site in the genome. The viral infection efficiency is known due to the existence of a cell wall in C. reinhardtii, which might limit viral uptake.
The Transposon System uses the transposase enzyme to cut the target gene sequence and select the marker out of the plasmid through recognition of the transposon ends; then, it randomly inserts the gene into the cell’s genome. To apply the transposon system, the plasmid should include the sequence to produce transposase, the target gene, and zeocin resistance gene flanked with recognizable transposon ends. These are designed in a single plasmid instead of separate plasmids, as it can decrease transform efficiency, which might prohibit two plasmids from existing in one cell at the same time.
4.3. Kill switch
To apply this engineered C. reinhardtii strain in real-life wastewater treatment, a kill switch must be designed to ensure safety [13]. As the purpose of this research, the growth rate of this engineered C. reinhardtii will be higher than it usually is, and it will consume more nitrogen. This is good in terms of wastewater treatment, but if it has been exposed to nature, this engineered species will be invasive. Invasive species may outcompete the native species in the area, threatening other species’ survival. The kill switch will prohibit its growth when it is exposed to nature.
A kill switch is designed to limit the living conditions of an organism. In this case, for engineered C. reinhardtii to only live in a wastewater treatment plant, anthropogenic gadolinium might be a viable element to design as a kill switch [14]. Gadolinium is often contained in medical waste that does not exist in natural water bodies. Designed with gadolinium as a kill switch, the engineered organism can only live in the wastewater treatment plant with gadolinium present, preventing it from becoming an invasive species in nature.
References
[1]. Akinnawo, Solomon Oluwaseun. "Eutrophication: Causes, consequences, physical, chemical and biological techniques for mitigation strategies." Environmental Challenges 12 (2023): 100733.
[2]. Reilly, M. “The case against land application of sewage sludge pathogens.” The Canadian journal of infectious diseases = Journal canadien des maladies infectieuses vol. 12, 4 (2001): 205-7. doi: 10.1155/2001/183583
[3]. Znad, Hussein, et al. "Bioremediation and nutrient removal from wastewater by Chlorella vulgaris." Ecological Engineering 110 (2018): 1-7.
[4]. Amaro, Helena M., et al. "Microalgae systems-environmental agents for wastewater treatment and further potential biomass valorisation." Journal of Environmental Management 337 (2023): 117678.
[5]. Tu, Chenghang, et al. "Nitrogen and phosphorus preferring photogranules regulate COD/TN by carbon fixation through superposition of Chlorophyta, Cyanobacteria and Chloroflexi." Chemical Engineering Journal (2025): 165607.
[6]. ElNaker, Nancy A et al. “Effect of hydraulic retention time on microbial community structure in wastewater treatment electro-bioreactors.” MicrobiologyOpen vol. 7, 4 (2018): e00590. doi: 10.1002/mbo3.590
[7]. Oruganti, Raj Kumar et al. “A comprehensive review on the use of algal-bacterial systems for wastewater treatment with emphasis on nutrient and micropollutant removal.” Bioengineered vol. 13, 4 (2022): 10412-10453. doi: 10.1080/21655979.2022.2056823
[8]. Yaakob, Maizatul Azrina et al. “Influence of Nitrogen and Phosphorus on Microalgal Growth, Biomass, Lipid, and Fatty Acid Production: An Overview.” Cells vol. 10, 2 393. 14 Feb. 2021, doi: 10.3390/cells10020393
[9]. Sanz-Luque, Emanuel et al. “Understanding nitrate assimilation and its regulation in microalgae.” Frontiers in plant science vol. 6 899. 26 Oct. 2015, doi: 10.3389/fpls.2015.00899
[10]. Severin Sasso, Herwig Stibor, Maria Mittag, Arthur R Grossman (2018) The Natural History of Model Organisms: From molecular manipulation of domesticated Chlamydomonas reinhardtii to survival in nature eLife 7: e39233
[11]. Huang, D., Liu, C., Su, M. et al. Enhancement of β-carotene content in Chlamydomonas reinhardtii by expressing bacterium-driven lycopene β-cyclase. Biotechnol Biofuels 16, 127 (2023). https: //doi.org/10.1186/s13068-023-02377-1
[12]. Hu, Xiaobing et al. “Application of transposon insertion site sequencing method in the exploration of gene function in microalgae.” Frontiers in microbiology vol. 14 1111794. 3 Feb. 2023, doi: 10.3389/fmicb.2023.1111794
[13]. Li, Xinyi et al. “A Rapid and Reversible Molecular "Switch" Regulating Protein Expression in Chlamydomonas reinhardtii.” Plant, cell & environment vol. 48, 6 (2025): 3913-3924. doi: 10.1111/pce.15360
[14]. Tomczuk, Marlena et al. “Gadolinium in the Environment: A Double-Edged Sword for Plant Growth and Ecosystem Stability.” Metabolites vol. 15, 6 415. 19 Jun. 2025, doi: 10.3390/metabo15060415
Cite this article
Yu,H. (2025). Genetic Engineering of Nitrate Assimilation in Chlamydomonas reinhardtii to Accelerate Growth for Algal Wastewater Treatment. Applied and Computational Engineering,200,76-90.
Data availability
The datasets used and/or analyzed during the current study will be available from the authors upon reasonable request.
Disclaimer/Publisher's Note
The statements, opinions and data contained in all publications are solely those of the individual author(s) and contributor(s) and not of EWA Publishing and/or the editor(s). EWA Publishing and/or the editor(s) disclaim responsibility for any injury to people or property resulting from any ideas, methods, instructions or products referred to in the content.
About volume
Volume title: Proceedings of CONF-MCEE 2026 Symposium: Advances in Sustainable Aviation and Aerospace Vehicle Automation
© 2024 by the author(s). Licensee EWA Publishing, Oxford, UK. This article is an open access article distributed under the terms and
conditions of the Creative Commons Attribution (CC BY) license. Authors who
publish this series agree to the following terms:
1. Authors retain copyright and grant the series right of first publication with the work simultaneously licensed under a Creative Commons
Attribution License that allows others to share the work with an acknowledgment of the work's authorship and initial publication in this
series.
2. Authors are able to enter into separate, additional contractual arrangements for the non-exclusive distribution of the series's published
version of the work (e.g., post it to an institutional repository or publish it in a book), with an acknowledgment of its initial
publication in this series.
3. Authors are permitted and encouraged to post their work online (e.g., in institutional repositories or on their website) prior to and
during the submission process, as it can lead to productive exchanges, as well as earlier and greater citation of published work (See
Open access policy for details).
References
[1]. Akinnawo, Solomon Oluwaseun. "Eutrophication: Causes, consequences, physical, chemical and biological techniques for mitigation strategies." Environmental Challenges 12 (2023): 100733.
[2]. Reilly, M. “The case against land application of sewage sludge pathogens.” The Canadian journal of infectious diseases = Journal canadien des maladies infectieuses vol. 12, 4 (2001): 205-7. doi: 10.1155/2001/183583
[3]. Znad, Hussein, et al. "Bioremediation and nutrient removal from wastewater by Chlorella vulgaris." Ecological Engineering 110 (2018): 1-7.
[4]. Amaro, Helena M., et al. "Microalgae systems-environmental agents for wastewater treatment and further potential biomass valorisation." Journal of Environmental Management 337 (2023): 117678.
[5]. Tu, Chenghang, et al. "Nitrogen and phosphorus preferring photogranules regulate COD/TN by carbon fixation through superposition of Chlorophyta, Cyanobacteria and Chloroflexi." Chemical Engineering Journal (2025): 165607.
[6]. ElNaker, Nancy A et al. “Effect of hydraulic retention time on microbial community structure in wastewater treatment electro-bioreactors.” MicrobiologyOpen vol. 7, 4 (2018): e00590. doi: 10.1002/mbo3.590
[7]. Oruganti, Raj Kumar et al. “A comprehensive review on the use of algal-bacterial systems for wastewater treatment with emphasis on nutrient and micropollutant removal.” Bioengineered vol. 13, 4 (2022): 10412-10453. doi: 10.1080/21655979.2022.2056823
[8]. Yaakob, Maizatul Azrina et al. “Influence of Nitrogen and Phosphorus on Microalgal Growth, Biomass, Lipid, and Fatty Acid Production: An Overview.” Cells vol. 10, 2 393. 14 Feb. 2021, doi: 10.3390/cells10020393
[9]. Sanz-Luque, Emanuel et al. “Understanding nitrate assimilation and its regulation in microalgae.” Frontiers in plant science vol. 6 899. 26 Oct. 2015, doi: 10.3389/fpls.2015.00899
[10]. Severin Sasso, Herwig Stibor, Maria Mittag, Arthur R Grossman (2018) The Natural History of Model Organisms: From molecular manipulation of domesticated Chlamydomonas reinhardtii to survival in nature eLife 7: e39233
[11]. Huang, D., Liu, C., Su, M. et al. Enhancement of β-carotene content in Chlamydomonas reinhardtii by expressing bacterium-driven lycopene β-cyclase. Biotechnol Biofuels 16, 127 (2023). https: //doi.org/10.1186/s13068-023-02377-1
[12]. Hu, Xiaobing et al. “Application of transposon insertion site sequencing method in the exploration of gene function in microalgae.” Frontiers in microbiology vol. 14 1111794. 3 Feb. 2023, doi: 10.3389/fmicb.2023.1111794
[13]. Li, Xinyi et al. “A Rapid and Reversible Molecular "Switch" Regulating Protein Expression in Chlamydomonas reinhardtii.” Plant, cell & environment vol. 48, 6 (2025): 3913-3924. doi: 10.1111/pce.15360
[14]. Tomczuk, Marlena et al. “Gadolinium in the Environment: A Double-Edged Sword for Plant Growth and Ecosystem Stability.” Metabolites vol. 15, 6 415. 19 Jun. 2025, doi: 10.3390/metabo15060415









